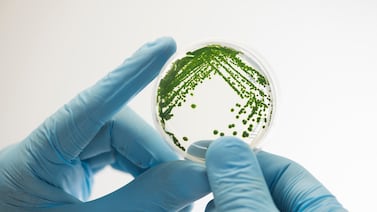
Estancada, centralizada y con brechas de género: 5 claves para entender la graduación STEM en Costa Rica

La titulación universitaria en carreras de ciencia, tecnología, ingeniería y matemáticas (STEM) no despega. En los últimos 10 años, la proporción de graduados se mantiene en torno al 30%, concentrada en la Región Central y marcada por brechas de género y cierta dependencia de las ‘u’ públicas